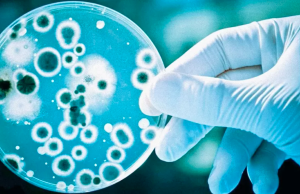
Antibiótico capaz de matar superbactéria é descoberto com ajuda de IA

Monalisa
Muro de cemitério desaba e ossadas ficam expostos em Santos, SP
Parte do muro do Cemitério da Filosofia, em Santos, na Baixada Santista, desabou após uma forte chuva na madrugada desta segunda-feira (29) e deixou...
Droga K tem anestésico e anabolizante de cavalo em sua composição
Traficantes estão usando anestésico e anabolizante de cavalo para produzir o coquetel químico que é vendido como se fosse uma “maconha sintética”,...
Antibiótico capaz de matar superbactéria é descoberto com ajuda de IA
Cientistas do Canadá, descobriram um antibiótico capaz de matar uma espécie mortal de superbactéria com a ajuda de inteligência artificial (IA). O medicamento experimental,...
Homem invade hospital e atira contra ex-companheira, no DF
Um homem invadiu um hospital particular em Ceilândia, no Distrito Federal, e atirou cinco vezes contra a ex-companheira.
A vítima...
São Vicente, SP abre mais de 900 vagas para cursos livres...
As inscrições para cursos livres de diferentes modalidades e formação cultural, estarão abertas a partir de segunda-feira (29), em São Vicente, na...
Dois estelionatários são presos com cartão clonado em Santos, SP
Dois homens, de 34 e 38 anos, foram presos em flagrante por estelionato em Santos, na baixada Santista. Os itens em posse dos...